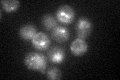
YKL209C
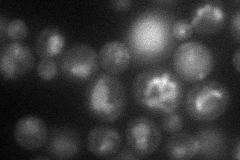
YKL209C
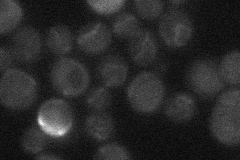
YKL209C
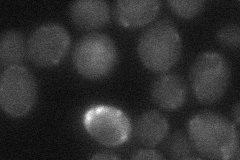
YKL209C

View description
Plasma membrane ATP-binding cassette (ABC) transporter required for the export of a-factor, catalyzes ATP hydrolysis coupled to a-factor transport; contains 12 transmembrane domains and two ATP binding domains; expressed only in MATa cells
Localization:
Intensity:
Fold change:
Significance:
-
C’ GFP library in SD
vacuole37.1 -
N' NOP1pr-GFP in SD
vacuole28.3175 -
N' TEF2pr-mCherry in SD

vacuole38.3696 -
N' NATIVEpr-GFP in SD
below threshold19.1982 -
N' TEF2pr-VC and Cyto-VN in SD
below threshold24.8356 -
C’ GFP library in SD+DTT

vacuole22.840.61Yes -
C’ GFP library in SD+H2O2

vacuole26.80.72No -
C’ GFP library in Starvation Media

vacuoleN/AN/AYes -
C’ GFP library on the background of Pup2-DaMP

vacuole -
C’ GFP library on the background of CCT mutant

vacuole27.48890.740792No
